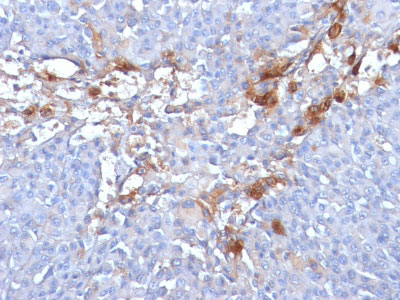

> Antigen, Antibodies, ELISA, Western Blot > Primary Antibody > Monoclonal Antibodies > MUC18 / CD146 / MCAM (Melanoma Cell Adhesion Molecule) Antibody - Without BSA and AzideBrand |
Leading Biology | Catalog Number |
AMM01015G |
Product Type |
Monoclonal Antibodies | Field of Research |
|
Product Overview |
We constantly strive to ensure we provide our customers with the best antibodies. As a result of this work we offer this antibody in purified format.
We are in the process of updating our datasheets. If you have any questions regarding this update, please feel free to contact our technical support team.
This product is a high quality MUC18 / CD146 / MCAM (Melanoma Cell Adhesion Molecule) Antibody - Without BSA and Azide.
|
||
Molecular Weight |
130kDa
|
||
Cellular Localization |
Antigen Cellular Localization:
Membrane; Single-pass type I membrane protein
|
||
Host |
Mouse
|
||
Species Reactivity |
Human
|
||
Clone |
MUC18/1130
|
||
Isotype |
Mouse / IgG1, kappa
|
||
Symbol |
MUC18
|
||
GeneID |
|||
UniProt ID |
|||
Function |
Plays a role in cell adhesion, and in cohesion of the endothelial monolayer at intercellular junctions in vascular tissue. Its expression may allow melanoma cells to interact with cellular elements of the vascular system, thereby enhancing hematogeneous tumor spread. Could be an adhesion molecule active in neural crest cells during embryonic development. Acts as surface receptor that triggers tyrosine phosphorylation of FYN and PTK2/FAK1, and a transient increase in the intracellular calcium concentration.
|
||
Summary |
The human Mel-CAM gene maps to chromosome 11q23 and encodes a trans-membrane glycoprotein, also designated MCAM, MUC 18 or CD146, that belongs to the immunoglobulin superfamily and functions as a Ca2+-independent cell adhesion molecule. Mel-CAM expression is restricted to advanced primary and metastatic melanomas and to cell lines of the neuroectodermal lineage, but not normal melanocytes. Mel-CAM is found on 80% of advanced primary human melanomas and correlates well with development of metastatic disease.
|
||
Form |
Liquid |
||
Storage & Stability |
Store at +4°C short term. For long-term storage, aliquot and store at -20°C or below. Stable for 12 months at -20°C. Avoid repeated freeze-thaw cycles.
|
||
Applications |
IHC, IF, FC
|
||
Images |

Formalin-fixed, paraffin-embedded human Melanoma stained with MUC18 Monoclonal Antibody (MUC18/1130)
Formalin-fixed, paraffin-embedded human Melanoma stained with MUC18 Monoclonal Antibody (MUC18/1130) 
Formalin-fixed, paraffin-embedded human Tonsil stained with MUC18 Monoclonal Antibody (MUC18/1130) |
||
Specification |
|||
Quantity |
|
||
| Select | Brand | Catalog No. | Product Name | Pack Size | Type | Field of Research | Specification | Quantity | Price(USD) | |
| 1 | Leading Biology | APG02467G | CCK4 / PTK7 Antibody (clone 4F9) | 50 μl | Monoclonal Antibodies |
|
$495.00 | Add Ask | ||
| 2 | Leading Biology | AMM04683G | GALT Antibody (clone 4C11) | 50 μg | Monoclonal Antibodies |
|
$545.00 | Add Ask | ||
| 3 | Leading Biology | AMM01402G | Vimentin (Mesenchymal Cell Marker) Antibody - With BSA and Azide | 50 ug | Monoclonal Antibodies |
|
$395.00 | Add Ask | ||
| 4 | Leading Biology | APR08280G | LTA4H / LTA4 Antibody (clone 9G8) | 50 μl | Monoclonal Antibodies |
|
$495.00 | Add Ask | ||
| 5 | Leading Biology | AMM00172G | CD1a / HTA1 (Mature Langerhans Cells Marker) Antibody - With BSA and Azide | 50 ug | Monoclonal Antibodies |
|
$395.00 | Add Ask | ||
| 6 | Leading Biology | AMM05750G | CEBPA Antibody | 100 μl | Monoclonal Antibodies |
|
$545.00 | Add Ask |
 Leading Biology Inc.
2600 Hilltop DR, Building G, B Suite C138
Richmond, CA, 94806
Tel: 1-661-524(LBI)-0262
Email: info@leadingbiology.com
Leading Biology Inc.
2600 Hilltop DR, Building G, B Suite C138
Richmond, CA, 94806
Tel: 1-661-524(LBI)-0262
Email: info@leadingbiology.com
Complete this form and click send to ask us a question, request a quote or simply say hello.

You have 0 item in your cart

You have 0 item in your inquiry list
